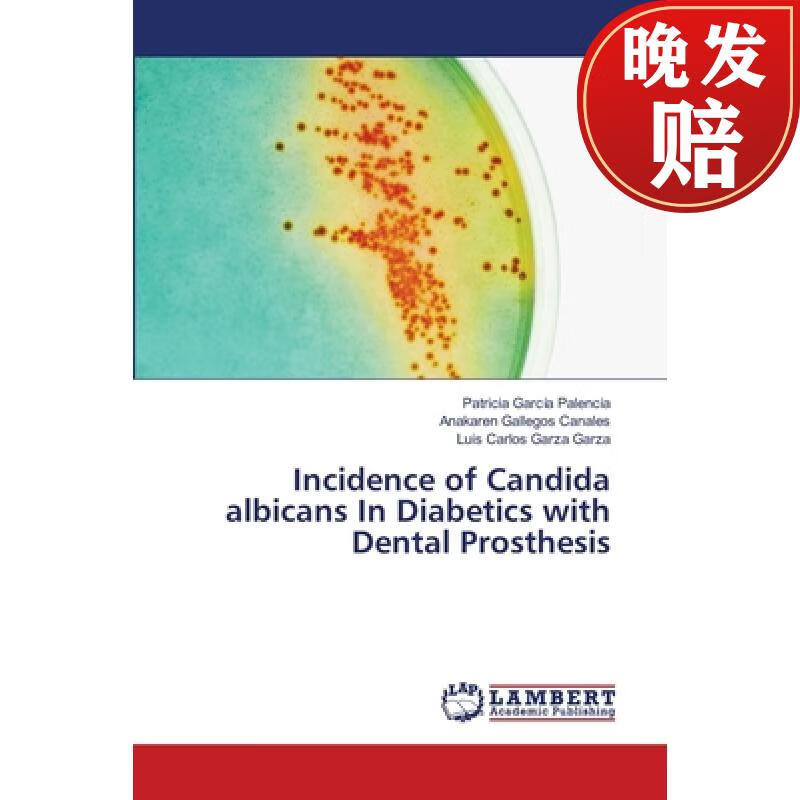
【4周达】incidence of candida albicans in diabetics with dental

candida

the candida cure: the 90-day program to balance your gut, beat
图片尺寸600x800
葱莲zephyranthes candida.又名玉帘,葱兰等.原产南美洲.
图片尺寸700x1051
海外直订医药图书candida: 10 lessons that will teach you how to
图片尺寸800x800
【预售 按需印刷】the career of candida
图片尺寸959x1360
文字海报版式设计
图片尺寸1080x1440
海外直订医药图书candida: the ultimate candida cure guide to
图片尺寸800x800
candida royalle
图片尺寸310x496
坎迪达·罗亚尔 ( candida royalle)
图片尺寸300x450
arbuthnot-leslie,是他们家族leslie clan的族长,她妈妈candida
图片尺寸500x568
【预订】the genetics of candida
图片尺寸347x499
candida pro bold version 2.00图片样张
图片尺寸360x270
【预售按需印刷】candida free cookbook
图片尺寸907x1360
40max. weekendcandida风衣原价 € 659(-40%)€ 395.40max.
图片尺寸410x410
candida moss to present 2013 colliver lecture sept. 19
图片尺寸445x539
all about candida/candidiasis website
图片尺寸580x385
candida overgrowth
图片尺寸262x519
infp人士的复古派对onparanoiamagazine
图片尺寸998x1331
【4周达】incidence of candida albicans in diabetics with dental
图片尺寸400x400
预订 candida and candidamycosis
图片尺寸350x499
candida rose流派:new age新世纪语种:其他发行时间:2021-04-16唱片
图片尺寸300x300